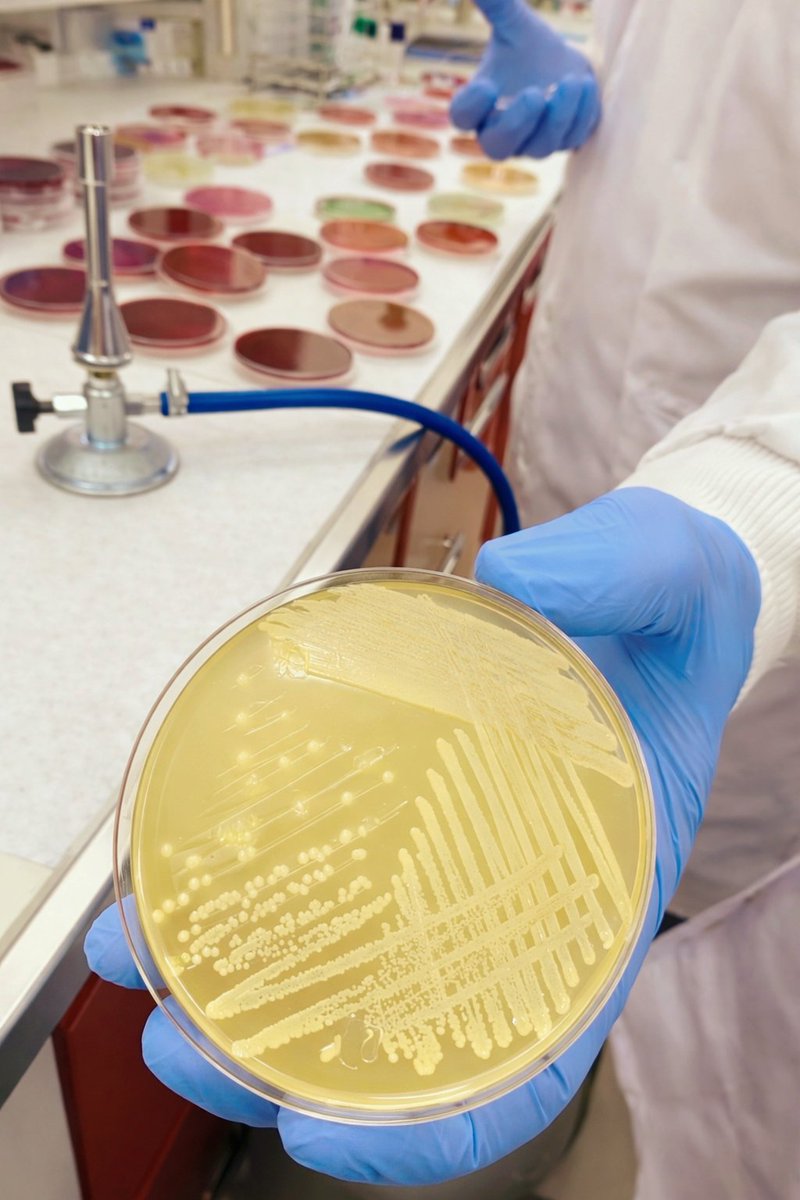
николь tweet media
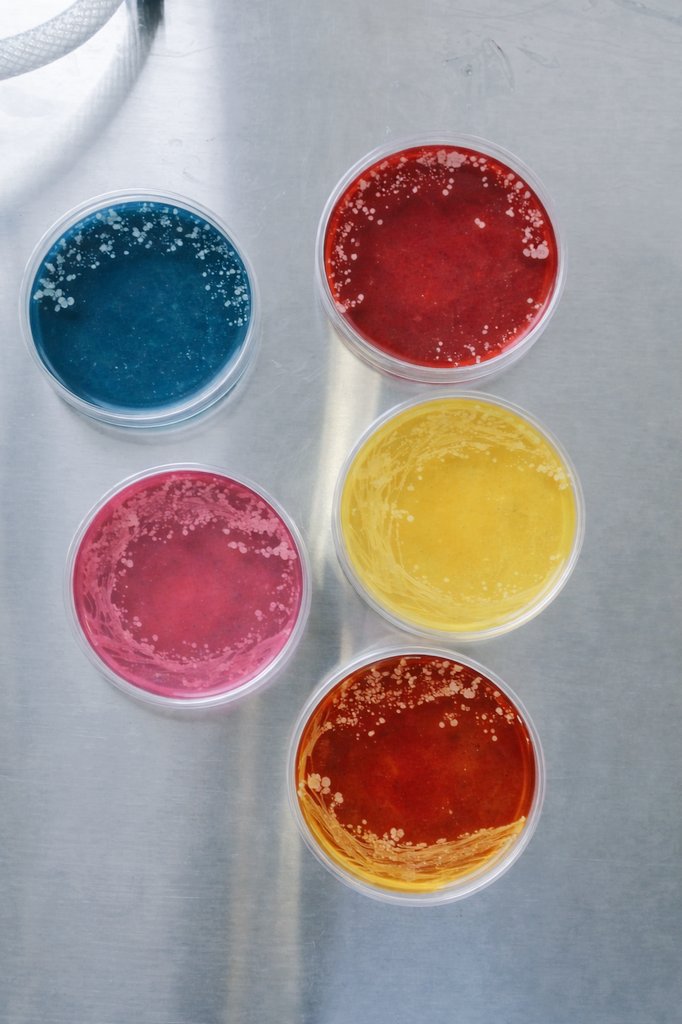
николь tweet media

Глеб Писаревский
2.6K posts


@gemi_softy Я так рыбу с фольгой съел... Оперировали, потому что застряла
Русский
Глеб Писаревский retweetledi

@pipocostein да блять заебали если честно. и немцы и евреи давно были ассимилированны. в них буквально нихуя не осталось своего, татары тоже только благодаря исламу сохранились
Русский

шутки шутками а если у вас нет еврейских корней то скорее всего вы действительно не русский
Здесь Шепелин@ilya_shepelin
Дудь: — Как твоя семья эмигрировала в Германию? Вайт Рекс: — По еврейской линии — То есть ты еврей? — Я предвидел этот вопрос! (достает свидетельство о рождении, где написано, что он не еврей)
Русский

@holliistic а ты ж в курсе что в общественных туалетах не какают
Русский
Глеб Писаревский retweetledi
Глеб Писаревский retweetledi

if u have to go through such a big changes while being old asf then u r mentally delayed or smth
Tommy Christie@tommyswriting
2020 2026 Weed every day Nicotine Agnostic God No Lifting Lifting 6x Corporate job No job
English

@sincerity_k8 помню в детстве мы так кристаллы делали какие-то
Русский

@nastyagirlsuper ужас состоит в том что прокрастинировать можно даже самых пиздецовых условиях.
Русский

@olgademark ну яж говорю каждый дрочит как он хочет. да и в сосисках тоже нет мяса лол.
Русский